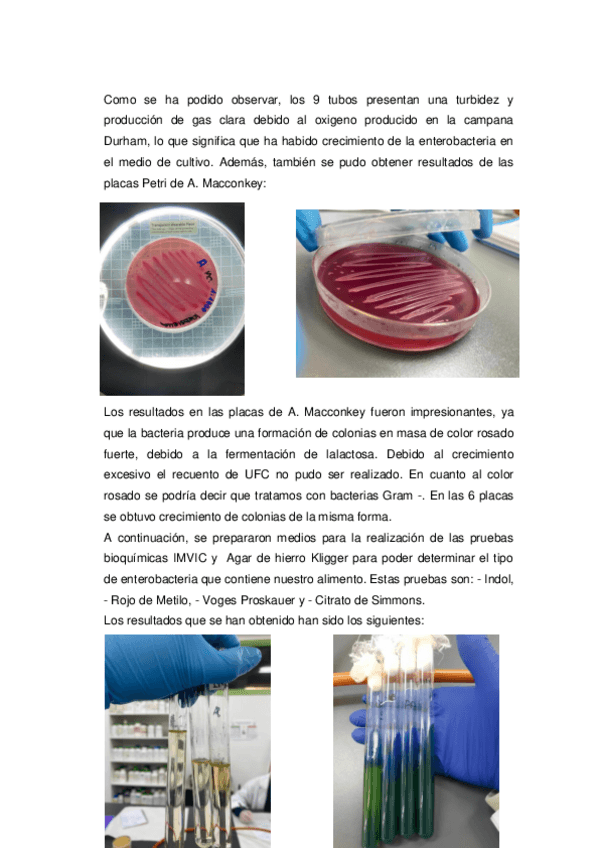

Control y vigilancia de la contaminación de alimentos
practicas
-
PRACTIQUES ALIMENTS
He publicado nuevos practicas de Control y vigilancia de la contaminación de alimentos: PRACTIQUES ALIMENTS
He publicado nuevos apuntes de Control y vigilancia de la contaminación de alimentos: Tema-8.pdf
He publicado nuevos apuntes de Control y vigilancia de la contaminación de alimentos: UT3-Calidad-y-Seguridad-de-los-alimentos.pdf
He publicado nuevos apuntes de Control y vigilancia de la contaminación de alimentos: Tema-5-Aditivos-alimentarios..pdf
He publicado nuevos apuntes de Control y vigilancia de la contaminación de alimentos: Tema-4-Contamiancion-de-los-alimentos.pdf
He publicado nuevos practicas de Control y vigilancia de la contaminación de alimentos: CorbelleAlonsoRaulP6-Identificacion-de-Salmonella.pdf
He publicado nuevos practicas de Control y vigilancia de la contaminación de alimentos: Corbelle-Alonso-Raul-P.-7-y-8.pdf
He publicado nuevos practicas de Control y vigilancia de la contaminación de alimentos: Corbelle-Alonso-Raul-PRACTICA-9.pdf
He publicado nuevos apuntes de Control y vigilancia de la contaminación de alimentos: TEMA-6.-Muestreo.pdf
He publicado nuevos apuntes de Control y vigilancia de la contaminación de alimentos: Tema-2-Grupos-de-Alimentos..pdf
He publicado nuevos apuntes de Control y vigilancia de la contaminación de alimentos: Tema-1-Alimentacion-y-nutricion..pdf
He publicado nuevos practicas de Control y vigilancia de la contaminación de alimentos: PRACTICA-5-Raul-Corbelle-Alonso..pdf
He publicado nuevos practicas de Control y vigilancia de la contaminación de alimentos: Practica-1-control-almidon.pdf
He publicado nuevos apuntes de Control y vigilancia de la contaminación de alimentos: Recuento-de-aerobios-mesofilos-revivificables.pdf
He publicado nuevos apuntes de Control y vigilancia de la contaminación de alimentos: Investigacion-de-Shigella-e-Investigacion-y-recuento-de-Staphylococcus-aureus.pdf
He publicado nuevos apuntes de Control y vigilancia de la contaminación de alimentos: Investigacion-de-la-Salmonella.pdf
He publicado nuevos apuntes de Control y vigilancia de la contaminación de alimentos: EXAMEN-PRACTICO-1o-EVALUACION-1.pdf
He publicado nuevos apuntes de Control y vigilancia de la contaminación de alimentos: Preguntas-Muestras-Control-e-higiene-de-los-alimentos-1.pdf
He publicado nuevos apuntes de Control y vigilancia de la contaminación de alimentos: Practica-2.-Determinacion-de-cenizas.pdf
He publicado nuevos apuntes de Control y vigilancia de la contaminación de alimentos: Determinacion-de-la-humedad.pdf
He publicado nuevos apuntes de Control y vigilancia de la contaminación de alimentos: UNIDAD-1.-ALIMENTACION-Y-NUTRICION.pdf
He publicado nuevos apuntes de Control y vigilancia de la contaminación de alimentos: LIMPIEZA.pdf
He publicado nuevos apuntes de Control y vigilancia de la contaminación de alimentos: Control-de-calidad.-Sistemas-APPCC.pdf
He publicado nuevos apuntes de Control y vigilancia de la contaminación de alimentos: CASO-PRACTICO-TRAZABILIDAD.docx
He publicado nuevos apuntes de Control y vigilancia de la contaminación de alimentos: Alerta-Sanitaria.pptx
He publicado nuevos apuntes de Control y vigilancia de la contaminación de alimentos: Adulteraciones-Y-Fraude-Cafe-1.docx
He publicado nuevos apuntes de Control y vigilancia de la contaminación de alimentos: Efectos-toxicos-de-algunos-componentes-alimentarios.docx
He publicado nuevos apuntes de Control y vigilancia de la contaminación de alimentos: VOCABULARIO-TEMA-3-Isabel-1.docx
He publicado nuevos apuntes de Control y vigilancia de la contaminación de alimentos: Tema-9-Isabel.pdf
He publicado nuevos apuntes de Control y vigilancia de la contaminación de alimentos: Requisitos-de-proveedores-de-servicios-biocidas.docx
He publicado nuevos apuntes de Control y vigilancia de la contaminación de alimentos: Metodos-de-control-de-aves-urbanas.pdf
He publicado nuevos apuntes de Control y vigilancia de la contaminación de alimentos: metodos-de-conservacion-2.pdf
He publicado nuevos apuntes de Control y vigilancia de la contaminación de alimentos: Situacion-de-control-de-plagas-en-Espana.docx
He publicado nuevos apuntes de Control y vigilancia de la contaminación de alimentos: Requisitos-de-los-servicios-de-control-de-plagas.docx
He publicado nuevos apuntes de Control y vigilancia de la contaminación de alimentos: Lucha-Integrada-2.docx
He publicado nuevos apuntes de Control y vigilancia de la contaminación de alimentos: B4T3.pdf
He publicado nuevos apuntes de Control y vigilancia de la contaminación de alimentos: PRACTICA-7.docx
He publicado nuevos apuntes de Control y vigilancia de la contaminación de alimentos: Cuestionario-CVC-2.pdf
apuntes
-
Práctica (libro microbiología)
He publicado nuevos apuntes de Control y vigilancia de la contaminación de alimentos: Práctica (libro microbiología)
apuntes
-
Teoría de la práctica (apuntes amparo)
He publicado nuevos apuntes de Control y vigilancia de la contaminación de alimentos: Teoría de la práctica (apuntes amparo)
apuntes
-
Teoría (Javier)
He publicado nuevos apuntes de Control y vigilancia de la contaminación de alimentos: Teoría (Javier)
He publicado nuevos apuntes de Control y vigilancia de la contaminación de alimentos: 00081635.doc

¡Estás al día!
Has visto todos los archivos